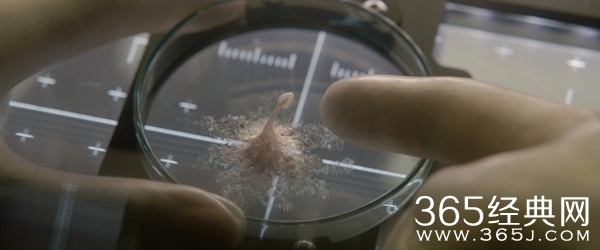

播出时间:2017-05-19
由杰克·吉伦哈尔、丽贝卡·弗格森、瑞安·雷诺兹等主演的科幻惊悚电影《异星觉醒》(原译名《生命》)今日全球同步首发中文国际版预告片。神秘样本竟是外星智慧生命线索,新发现令一众宇航员十分兴奋,但不知其暗含致命杀机,整个空间站岌岌可危,配乐和剪辑则透露着影片惊悚的气氛。
影片将于2017年5月26日上映,敬请期待。

最新消息
《异星觉醒》挟爆棚的国外口碑之势,《异星觉醒》将成为2017年最令人屏气凝神的惊悚太空灾难巨制,于5月19日再掀电影热潮。据悉,《异星觉醒》是心理惊悚元素和太空探索题材的完美融合,看过影片的观众表示,影片既像《釜山行》,也像《生化危机》系列电影,重要的是结合了太空的元素,让这种惊悚灾难达到了一个更高的层次。
中文海报上“人类的一大步,可能是它的第一步”套用首位登月宇航员的名言,直接点出外星生物可能带来灭世灾难的主题,而三位宇航员面对未知的黑暗世界严阵以待,隐含的灭世危机触目惊心。
同时发布的全新预告片则带观众步入这场太空灾难梦魇。外星生命从沉睡到被唤醒生长,场景精美绝伦令人赞叹。但长大的高智商外星生物同样为了生存,如影随形无处不在,营造出巨大的心理压迫感,而逃生舱回到地球,更令灭世浩劫箭在弦上一触即发。
影片简介
本次曝光的预告片表明人类有意识联系外星文明,历经20年火星探测车采集到“神秘样本”,宣布人类与外星生命体终于建立联系。这一奇迹般的发现使宇航员们“欣喜若狂”,但噩梦竟也悄然而至。“如果让它抵达地球,那整个人类都会面临威胁”这样冷酷直白的话语不禁让人毛骨悚然,恐惧直入心底。
外星生命体攻击宇航员后竟神秘消失,刺耳尖锐的警铃声,偏离轨道的空间站表示外星生命体对人类来说凶险万分;宇航员们惊慌失措的眼神和痛苦万分的呻吟则昭示着他们命悬一线的艰难处境。危险降临整个空间站,宇航员们的命运走向如何?人类又究竟该如何与外星生命相处?无疑成为影片最大悬念。与国际版预告片不同,美国版特别展现了外星生物的画面,惊悚指数更为升级。
演员介绍
本片演员阵容星和幕后制作团队都是国际一流,由曾主演过《断背山》、《源代码》等一系列口碑票房双炸裂的杰克·吉伦哈尔担任主演,而另一位主角为曾主演《死侍》的瑞安·雷诺兹。女主角丽贝卡·佛格森则曾加盟《碟中谍5:神秘国度》。曾制作过《星际迷航》、《侠探杰克》、《碟中谍》等经典影片的天空之舞制片公司制作。《死侍》编剧略特·里斯和保罗·韦尼克操刀剧本,由《僵尸世界大战》、《拯救大兵瑞恩》、《变形金刚》等电影制片人伊恩·布莱斯担当制片。
预告片欣赏
精彩预告片,请点击观看
重要提醒
本片已经有播放资源,点击在线观看就可以观看。但本网站不提供下载和在线播放,会跳转至相关版权网站播放。
影片剧照

更多精彩内容,请持续关注365经典网。
